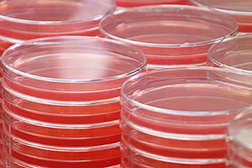
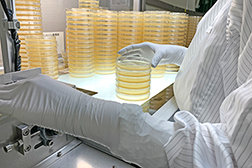

培地の豆知識
分画培地
分画培地とは?
分画培地は、複数枚の培地を使用して分離培養を行う際の省力化、省スペース化を目的に考案されました。90mmシャーレの内部に培地が混ざらないように隔壁(仕切り)が設けられ、それぞれの区画に通常異なる培地が充填されています。分画培地には、シャーレ中央で2等分した区画に2種類の培地を充填した2分画培地のほか、3分画培地、4分画培地などの種類があります。
2分画培地

分画培地は、当初仕切りが培地面より高いタイプが開発されました。省スペース化を目的に、目的が異なる培地を組み合わせる、あるいは同じ培地を充填することもあります。
仕切りが高い2分画培地では、検体はそれぞれの培地へ別々に2回、塗抹しなければなりません。分離培養には独立コロニーを得ることが重要で、そのためには一定の培地面積が必要ですが、省スペースになった分、培地面積も従来の平板培地に比べ1/2になっていますので、使用においては注意が必要です。
低仕切り2分画培地
2分画培地が開発され間もなくして、2種類の培地に同時に塗抹したいという要求が生まれます。仕切りの高さに合わせて培地を充填する工夫がなされ、「低仕切り2分画培地」が考案され、現在では2分画培地の主流となっています。
2種類の培地に同時に塗抹できるようになり、今までの高仕切り2分画培地の単なる省スペース化から、さらに様々なメリットが付加されます。
検体を2つの培地に1枚の平板培地のように一度に塗抹できるので、作業の効率化が図れると同時に、塗抹した軌跡に発育した(または発育しない)コロニーの状態を2つ同時に比較して観察できるため、2枚のシャーレを用いるよりも選択分離・鑑別精度が高まることがあります。
分画培地の組み合わせ、使用目的のまとめ
- 目的が異なる選択培地の組み合わせ、同じ培地の組み合わせ
→ 省力・省スペース化 - 選択培地と非選択培地の組み合わせ(低仕切り2分画培地)
→ 選択分離培養・鑑別に加え、微生物が存在していることが確認できる - 目的が同じで選択機構が異なる培地の組み合わせ(低仕切り2分画培地)
→ 鑑別する項目を増やし選択分離・鑑別精度を上げることができる
3分画、4分画培地の使用目的
2分画培地に比べ塗抹面積はさらに狭まり、分離培養には不向きです。分離培養のためではなく、目的とする微生物の複数の鑑別項目を判定できる培地を組み合わせて使用されることが多いです。
異なる濃度の抗生物質を含む培地を組み合わせて、薬剤感受性を大まかに知る目的などにも使用されます。
培地の滅菌方法
培地に用いられる滅菌方法について

培地調製において「滅菌」は、大変重要な工程です。非選択培地、選択培地にかかわらず、基礎となる培地成分は正しく滅菌されていなければなりません。これらの滅菌方法としては、高圧蒸気滅菌が古くから用いられており、加熱によってすべての微生物を殺滅し無菌状態を得るという方法がとられています。基礎となるペプトン、エキス、塩類、寒天などの培地成分は、一定の耐熱性のあるものが選ばれていますが、それらの成分も過加熱によって劣化するため、培地調製においてはしっかりとした加熱の温度、時間を管理することが必要です。
培地成分のうち、抗生物質などの熱に弱い成分は、メンブランフィルターでろ過して滅菌する方法が用いられます。
ガンマ線照射培地
環境モニタリングに使用される培地
医薬品工場等のクリーンルームの環境モニタリングに、ガンマ線照射した培地がよく用いられています。平板培地用シャーレまたはスタンプ培地用シャーレに培地を無菌充填し、2重または3重に多重包装され、包装資材ごとガンマ線照射し滅菌しています。包装内部の無菌性が保証されており、パスボックス内で培地包装袋を開封し、クリーンルームに持ち込みます。
これらの製品は、「無菌医薬品製造区域の環境モニタリング法」(第十七改正日本薬局方 参考情報※)の 5. 微生物測定に基づいて使用され、ソイビーン・カゼイン・ダイジェスト培地(SCD寒天培地)やレシチン・ポリソルベート80添加ソイビーン・カゼイン・ダイジェスト培地(SCDLP寒天培地)がよく用いられます。
本基準の5.1.1. 浮遊菌数測定においては、エアサンプラーに設置するための平板培地が、また、5.1.2 表面付着菌数測定においては、コンタクトプレート法としてスタンプ培地が用いられます。
充填試験用濃縮培地
培地充填試験とは、無菌的に製造される医薬品(または、飲料などの食品)の無菌性を検証するため、充填物の代わりに無菌培地を充填し、充填ラインや作業環境を含めた充填工程の適切性をバリデートする一方法です。
医薬品分野では「培地充填試験(プロセスシミュレーション)」(第十七改正日本薬局方 参考情報※)の方法に沿ってSCD液体培地が使用されます。食品分野では、培地組成をSCD液体培地から適切な培地に変更することで、ペットボトル飲料などのラインの充填試験のような商業的無菌性の検証に用いられています。
※上記の参考情報は、第十七改正日本薬局方第2追補(令和元年6月28日)で削除されましたが、同日付厚労省事務連絡にて、引き続き、「無菌医薬品の製造等における参考に供するもの」とされています。
(https://www.pmda.go.jp/files/000230315.pdf)
培地の保管上の注意点
培地保管におけるpH変化について(培地色調の変化)
培地の劣化は製造直後から少しずつ始まり、培地のpHも経時的に変動していきます。
一般的に糖の利用によるpHの変化を鑑別点としている培地は、pH指示薬の変色域に培地のpHを設定していますので、少しのpH変化が、規格範囲内であっても色の違いとなって見える場合があります。製品に記された有効期限内であれば性能は保証されていますのでご安心してお使いください。
培地のpHは性能を発揮するための重要な要素です。所定の保管条件を外れる温度にさらされると、経時的劣化は早く進行します。劣化はまずpHに表れます。培地の保管において保管温度は厳守し、期限内でご使用ください。
保管時の密封の必要性
包装袋を開封後に残った培地を保管するときは、包装袋をヒートシールなどの方法で密封してください。
平板培地のシャーレは本体とフタの間に隙間があり、空気は流通します。シャーレ単体で、または密封せずに冷蔵庫に保管すると、培地は庫内の空気の影響を受けてしまいます。
一例として、卵黄加マンニット食塩寒天培地の保管中に培地の色が黄色に変化してしまったということが挙げられます。これは、酸性環境に放置されたことにより、培地が酸性側に傾き、組成中のpH指示薬であるフェノールレッドが赤色から黄色に変化したためです。ドライアイスを保管箱に入れ輸送した場合などで、包装袋が密封されていないと、揮発した二酸化炭素の影響で培地色が黄色に変色してしまいます。培地包装袋にピンホールがあった場合も同様に変色します。
寒天培地の表面の水分
寒天の水分は繊維の網目構造によって保持されていますが、それは強固なものではなく、寒天が凝固する時、また、温度変化があった時、網目内の水分は外に放出されます。寒天培地が凝固する時培地表面に現れる水分を「凝固水」、凝固後に放出された水分を「離漿水」、または「離水」と言います。微生物の発育において水分は重要で、適度に放出される水分は微生物に利用されますが、培地表面に過剰に存在する水分は集落の拡散の原因となります。寒天が凝固した後の離水をなるべく少なくすることが寒天培地を使用するうえで重要となります。
寒天培地の過剰な離水を少なくするには
シャーレの内側に大きな水滴がついていて、流れるまでになっている。こうなると寒天の離水が過剰に出てしまって培地中の水分は失われている状態で、本来の発育性能を発揮しなくなることがあります。
平板培地、試験管培地、共通に言えることですが、
・寒天培地に急激な温度変化を与えない。
・冷蔵保管庫からの出し入れはなるべく少なくする。
・輸送中に高い温度に放置しない。
・冷蔵保管庫内で冷気に直接当てない。
などに注意してお取り扱いください。
寒天培地の保管時によくある事故
寒天培地を保冷して保管、または輸送するときに発生する問題の一つとして、寒天培地の凍結があります。寒天培地が凍ってしまうと、網目構造が壊れて寒天は崩れ、保持している水分も外に流れ出してしまいます。平板培地や試験管培地を使用前に開封した時、外観上全部または一部がくずれている場合、凍結が原因の可能性が高いです。
冷蔵庫内の冷気吹き出し口の近くにおいて冷気が当たっていたり、輸送中にドライアイスと直に接していた場合に発生しますので特に注意してください。
製造委託に関するQ&Aコーナー
-
特注培地のオーダーロットサイズはどのくらいですか?
90mmシャーレ平板培地の場合、最大20,000枚/Lotの製造が可能ですが、最小100枚(培地量として2L)からお受けいたしますのでお気軽にお問い合わせください。
試験管培地の場合は100本から承ります。 -
納期はどのくらいかかりますか?
新規製品については、製品仕様によって異なりますが、一般的な既知の培地の場合で、仕様決定後最短で6週間ほどとなります。
-
製造委託した製品は継続して購入する必要がありますか?
スポットの特注もご相談のうえ対応させていただきます。
-
指定した培地原料や包装材料などで委託したいのですが、製造可能ですか?
可能です。お客様から支給いただいた原料、材料を用いた製品の実績も数多くあります。
-
寒天培地の包装単位を指定できますか?
お客様のご要望に応じて、5枚、または1枚単位でも包装いたします。
-

培地の品質管理について、培地の性能はどのように管理していますか?
製造された培地は、性状試験(外観確認やpH測定等)および性能試験(代表的な試験菌を接種し培養結果を確認)を行い品質保証しています。
-
培地の滅菌条件はどのようにしていますか?
滅菌機ごとにバリデーションを行い、効果の確認された滅菌条件で培地を滅菌しています。製品ごとのバリデーションも承ります。
